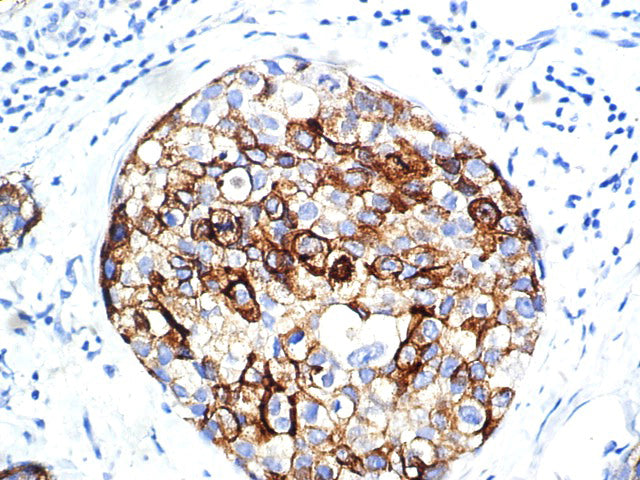
BCA-225 – MMab

BCA-225 – MMab
BCA-225 is a mouse monoclonal antibody derived from cell culture supernatant that is concentrated, dialyzed, filter sterilized and diluted in buffer pH 7.5, containing BSA and sodium azide as a preservative.
Intended Use
Summary and Explanation
Presentation
Choose options
BCA-225 – MMab
Sale priceFrom $158.00